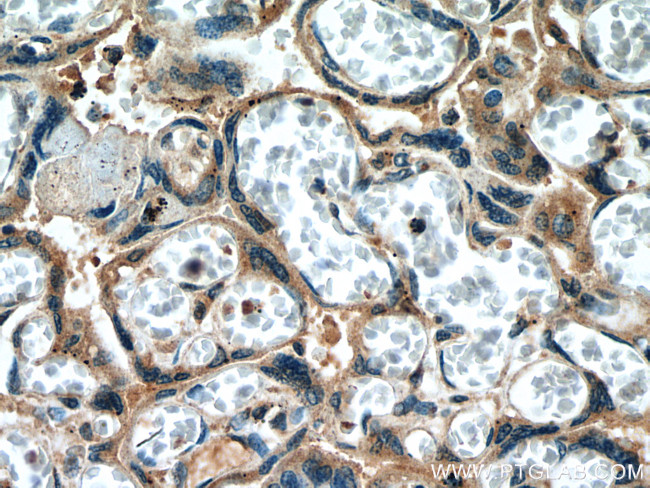
Collagen Type XI Antibody in Immunohistochemistry (Paraffin) (IHC (P))

Search
Proteintech
Collagen Type XI Polyclonal Antibody
{{$productOrderCtrl.translations['antibody.pdp.commerceCard.promotion.promotions']}}
{{$productOrderCtrl.translations['antibody.pdp.commerceCard.promotion.viewpromo']}}
{{$productOrderCtrl.translations['antibody.pdp.commerceCard.promotion.promocode']}}: {{promo.promoCode}} {{promo.promoTitle}} {{promo.promoDescription}}. {{$productOrderCtrl.translations['antibody.pdp.commerceCard.promotion.learnmore']}}
产品信息
21841-1-AP
种属反应
宿主/亚型
分类
类型
抗原
偶联物
形式
浓度
规格
纯化类型
保存液
内含物
保存条件
运输条件
产品详细信息
Aliquoting is unnecessary for -20°C storage.
靶标信息
Collagen Type XI is an 1806 amino acid protein belonging to the fibrillar collagen family. Collagen Type XI is thought to play an important role in fibrillogenesis by controlling lateral growth of collagen II fibrils. This protein forms trimers composed of three different chains: a 1(XI), a 2(XI), and a 3(XI). a 3(XI) is a post-translational modification of a 1(II). a 1(V) can also be found instead of a 3(XI). Collagen Type XI has three named isoforms (A,B,C) and additional isoforms seem to exist, stemming from alternative usage of exon IIA or exon IIB. Transcripts containing exon IIA or IIB are present in cartilage, but exon IIB is preferentially utilized in transcripts from tendon. Collagen Type XI contains a single collagen binding TSP N-terminal (TSPN) domain. Collagen Type XI is expressed in cartilage, placenta and some tumor or virally transformed cell lines. Isoform expression can be tissue specific. Defects in the COL11A gene are the cause of Stickler syndrome type 2 (STL2), or beaded vitreous type, due to the presence of irregularly thickened fiber bundles throughout vitreous cavity.
仅用于科研。不用于诊断过程。未经明确授权不得转售。
生物信息学
蛋白别名: alpha-1 (type XI) collagen precursor; COBA1; Collagen alpha 1; Collagen alpha-1(XI) chain; collagen XI, alpha-1 polypeptide; collagen, type XI, alpha 1; deafness, autosomal dominant 37; STL3; unnamed protein product; XI chain precursor
基因别名: CO11A1; COL11A1; COLL6; DFNA37; STL2
UniProt ID: (Human) P12107
Entrez Gene ID: (Human) 1301